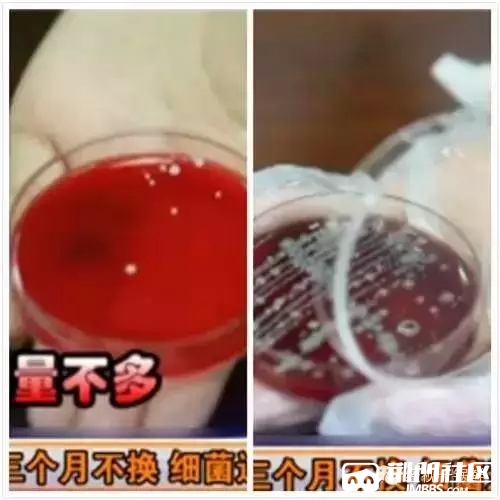
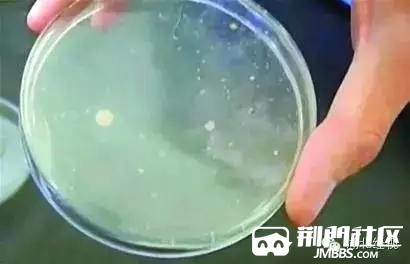

親,你的毛巾多久沒換了?半年?一年?還是沒破沒爛,堅決不換?可你知道一條舊毛巾里,含有多少細菌嗎?其中的綠膿桿菌和金黃葡萄球菌,甚至可以引起傷口化膿、痤瘡、粉刺,嚴重的可能爛臉……
實驗揭秘:毛巾三個月不換 細菌超千萬?
我們找到一條用了超長時間的舊毛巾,和一條剛換不久的毛巾,將它們送到實驗室進行細菌檢測。一號是用了很久的舊毛巾,二號是剛換不久的新毛巾,分別取出部分毛巾纖維,經(jīng)過處理后再放進恒溫箱,讓它們待上一晚,第二天早上再來看結(jié)果吧!

一天后↓↓↓
實驗結(jié)果:一號(舊毛巾)培養(yǎng)基里,竟然遍布著各種密密麻麻的細菌(右圖);二號(新毛巾)培養(yǎng)基里有細菌,但是數(shù)量不多,是正常的細菌(左圖)!

小心毛巾讓你毀容!
濕毛巾一個平方厘米有上千萬的細菌,整個菌落總數(shù)有十億。經(jīng)過鑒別,發(fā)現(xiàn)毛巾上面有大腸菌群,而大腸桿菌可以引起腹瀉。還有綠膿桿菌和金黃葡萄球菌,如果皮膚上有傷口可以引起化膿,還會引起痤瘡……

毛巾到底用多久換一次?
全國毛巾標準技術(shù)委員會秘書長稱,毛巾三個月就要及時更換一次。據(jù)悉,毛巾細菌容易滋生,四十天就超標了,使用達六個月,細菌會增萬倍。毛巾上常常沾染有人體分泌物,其中有許多致病性微生物,長期使用同一條毛巾會傳染多種疾病。

毛巾為何變成細菌的溫床?
1、毛巾的主要成分棉纖維是管狀結(jié)構(gòu),可儲存水分,濕度為細菌棲身提供了條件。
2、長期接觸水,經(jīng)常未晾干,因常被放在衛(wèi)生間里,濕熱環(huán)境更適合細菌生長。
3、人體皮膚上的油脂、皮屑等會堆積在毛巾上,很多人缺乏定期清洗的習慣,極易導(dǎo)致細菌成倍繁殖。
使用毛巾洗臉的正確方法
因為潮濕的環(huán)境是滋生細菌的溫床,專家建議我們洗臉的時候不要打濕毛巾擦臉,而是先用洗面奶和清水洗臉,然后再用毛巾擦干,盡量保持毛巾干燥。

如何給毛巾殺菌消毒
1、微波爐消毒。細菌**率達98%以上。將清洗后的毛巾放入微波爐專用保鮮盒,微波3~5分鐘即可。
2、中性洗滌劑消毒。用比較溫和無刺激的洗滌劑,能更好保持毛巾的柔軟性。
3、高溫消毒。沸水煮5分鐘,再用肥皂洗滌,最后用清水充分洗凈。
|